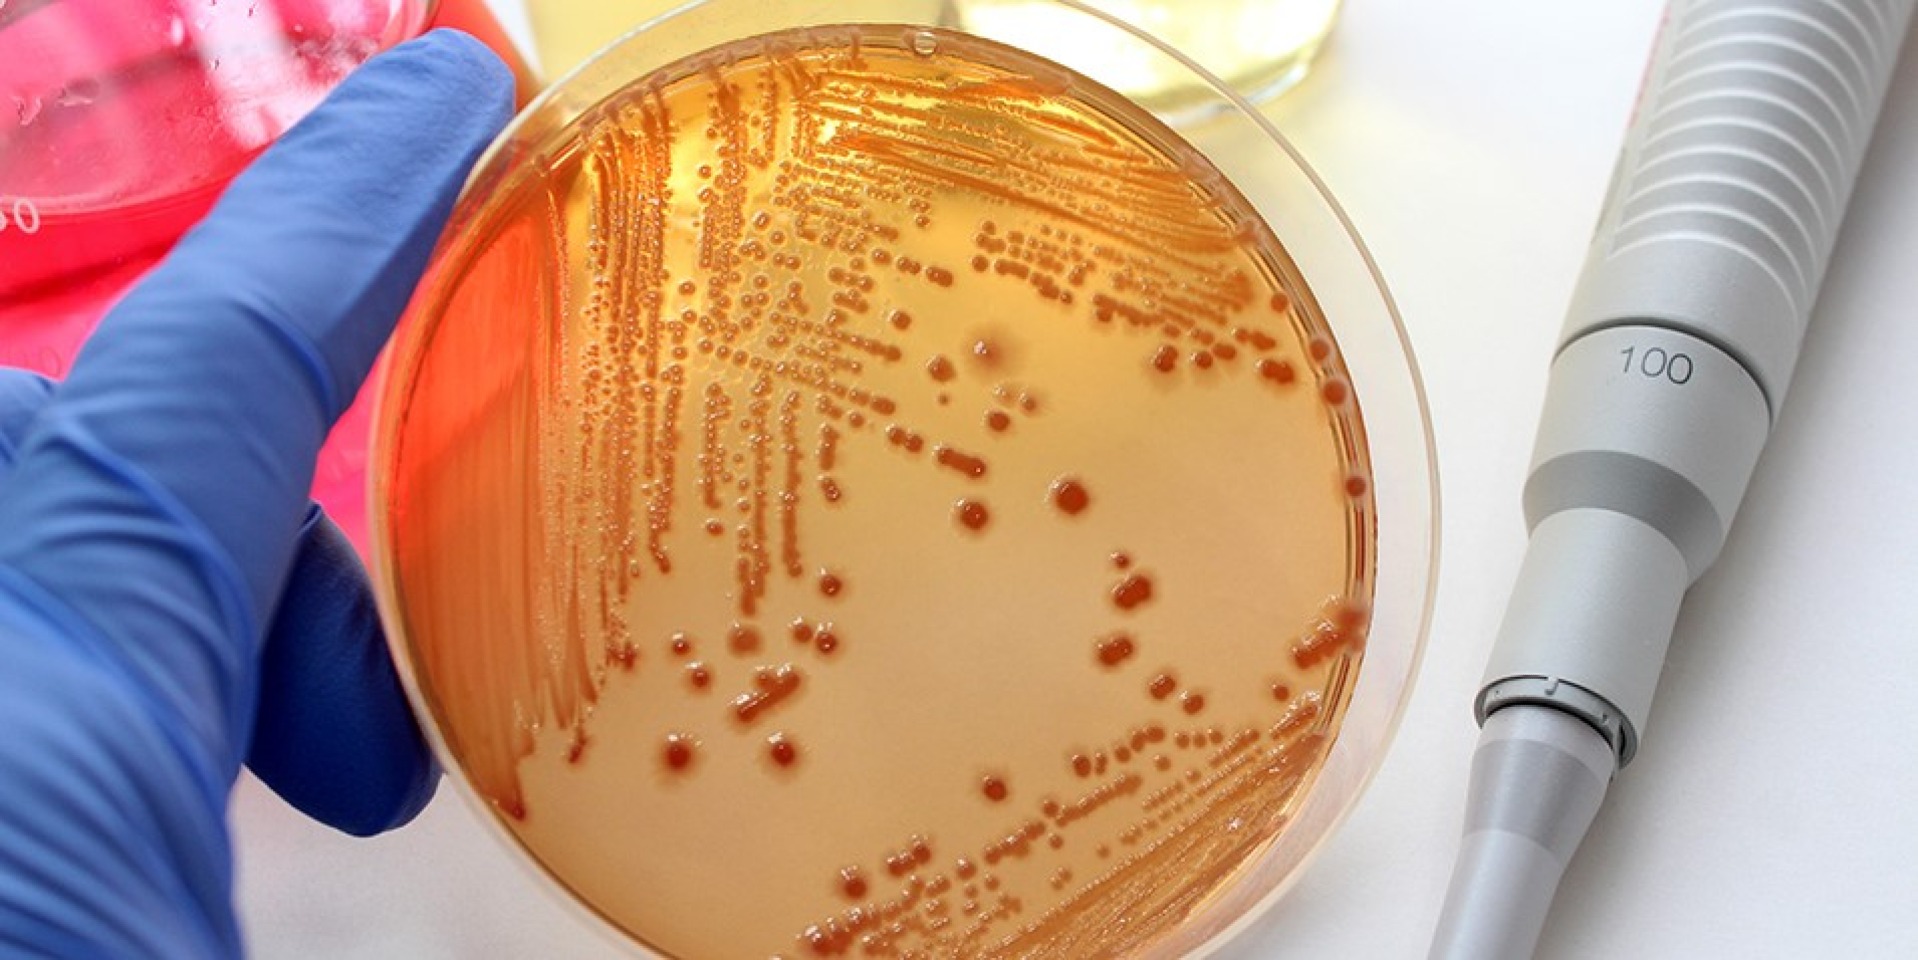
5 důležitých rad od mikrobiologa: Jak správně na antibiotika

5 důležitých rad od mikrobiologa: Jak správně na antibiotika
18. listopad je Evropským antibiotickým dnem a my si jej můžeme připomenout 5 důležitými radami od mikrobiologa.
V našem článku o správném užívání antibiotik nám radí vrchní lékařka oddělení lékařské mikrobiologie prachatické nemocnice MUDr. Eva Bžochová. Co tedy dělat nebo naopak nedělat, aby antibiotika fungovala?
- Neužívat antibiotika u virových onemocnění
Neužívejte antibiotika u častých respiračních onemocnění jako je rýma, zánět hltanu, chřipka, které jsou způsobeny viry. Antibiotika na viry nemají žádný vliv, nezkrátí vaše útrapy a naopak mohou nežádoucím způsobem ovlivnit vaši mikroflóru ve střevech, na kůži či na sliznicích. Tuto mikroflóru tvoří prospěšné, „hodné“ bakterie a narušení rovnováhy vašeho střevního mikrobiomu působením antibiotik se může projevit průjmy.
2. Neužívat antibiotika tzv. preventivně
ATB berte výhradně na základě diagnózy vašeho lékaře, ne v momentě, kdy žádnou infekcí netrpíte. Poškozujete si tím svoji přirozenou tělesnou mikroflóru a ještě „posilujete“ bakterie k odolnosti.
3. Dodržovat předepsané dávkování
Antibiotika užívejte tak, jak vám je předepsal lékař, a neukončujte léčbu, jakmile se vám udělá lépe, protože bakterie mohou být sice oslabené, ale „prošly tréninkem“ a příště „budou vědět“, jak na to. Ani si dávku sami nezvyšujte, abyste si „posílili“ léčbu. Také dodržujte intervaly dávkování předepsané lékařem.
4. Neužívat antibiotika jen na léčbu příznaků
Antibiotika slouží k tomu, aby se nemnožily bakterie v těle, a usnadňují tak vaší imunitě boj s infekcí. Nemá smysl je užívat na tzv. sražení horečky nebo kašel, který může být příznakem virózy.
5. Následky nesprávného užívání antibiotik
Pokud se používají antibiotika nesprávně, bakterie se jim přizpůsobují (např. vznikem mutací) a pak na ně působí hůře nebo vůbec. Říkáme, že bakterie se stávají rezistentními=odolnými vůči antibiotiku a my musíme použít tzv. rezervní antibiotika, u kterých si bakterie také mohou najít cestu, jak jejich účinek obejít. A protože antibiotik je k dispozici jen omezené množství, hrozí, že v budoucnosti je nebude čím nahradit. Vědci odhadují, že pokud se nezmění náš přístup k antibiotikům, v roce 2050 bude na světě tolik odolných bakterií, že lidé budou umírat na infekční onemocnění mnohem častěji než dnes…







